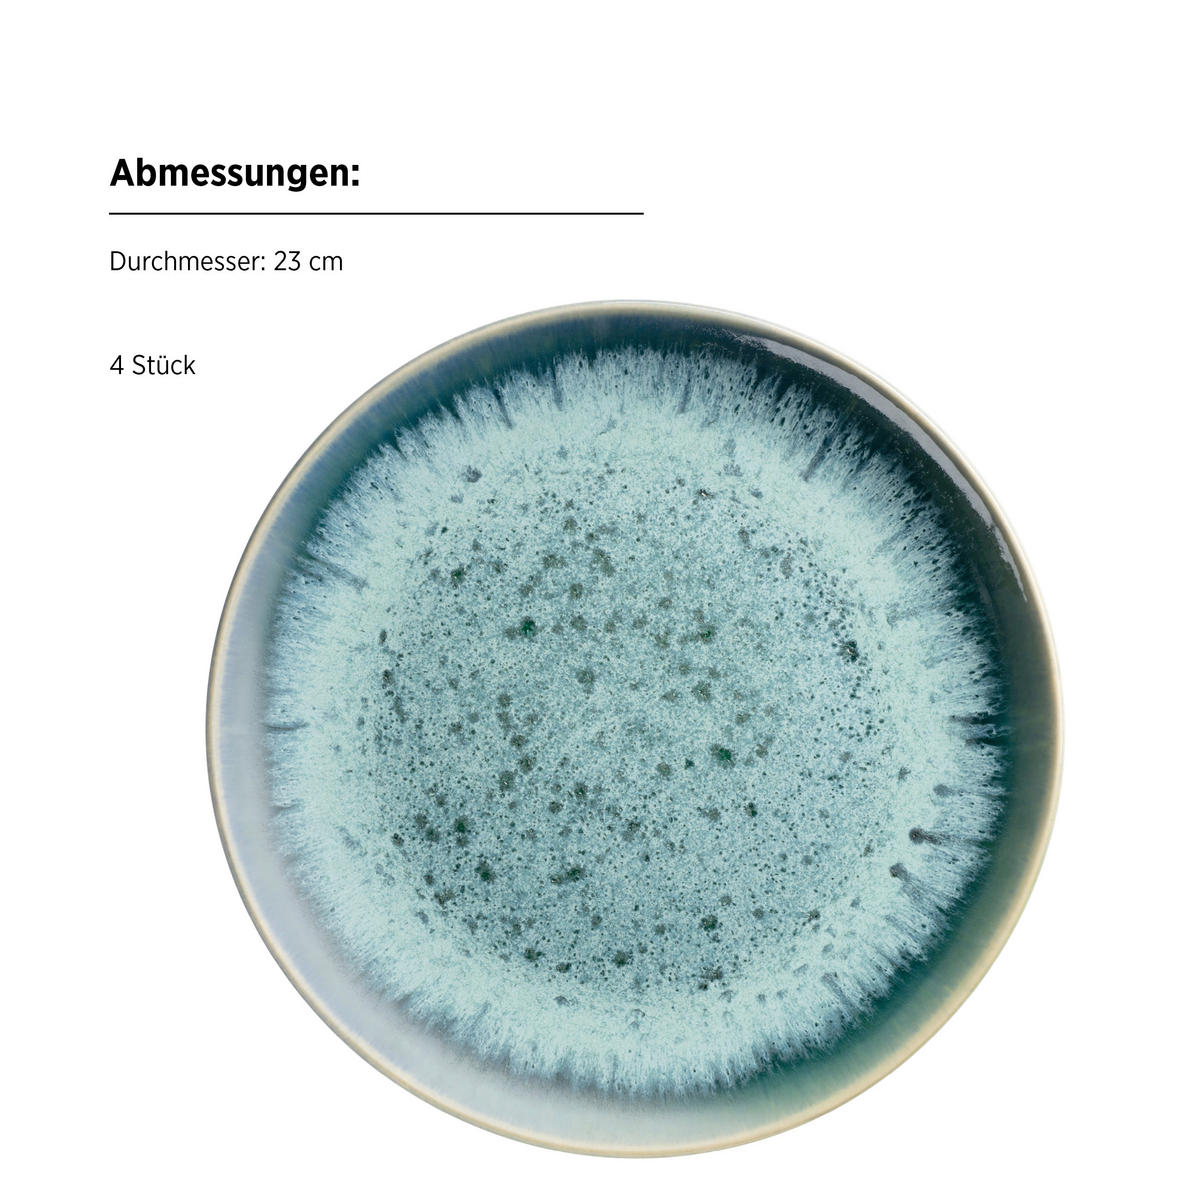
DESSERTTELLERSET Blau 4-teilig CARELLIA  - Blau, Basics, Keramik (23/2,4cm) - Mäser

Alle Preise in Euro und inkl. der gesetzlichen Mehrwertsteuer, ohne Deko, zzgl. Versandkosten. Lieferung nur innerhalb von Deutschland möglich. Änderungen und Irrtümer vorbehalten. *Stattpreis bezieht sich auf den uns vom Hersteller unverbindlich empfohlenen Preis. **Stattpreis bezieht sich auf unseren bisherigen Verkaufspreis. ***Filialpreis ohne Freundschaftskarte.